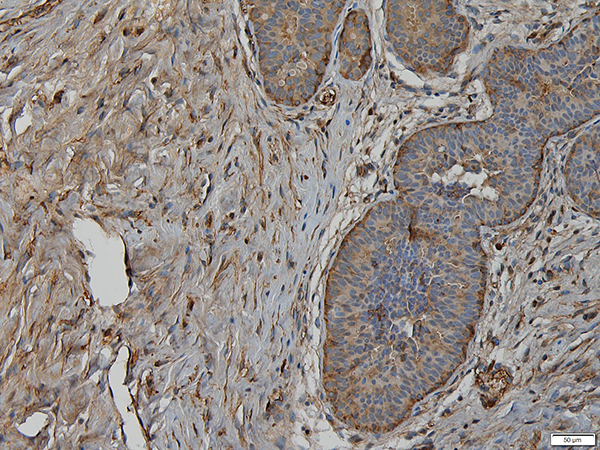

免疫组化 IHC
- 按需定制
- AtaGenix
- 湖北省武汉市
- 现货
- 按需定制
- 议价
- 2022-09-27 16:40:42
普健生物(武汉)科技有限公司
- 英文名称
- IHC
服务简介
IHC是应用免疫学基本原理抗原抗体反应,即抗原与抗体特异性结合的原理,通过化学反应使标记抗体的显色剂(荧光素、酶、金属离子、同位素)显色来确定组织细胞内抗原(多肽和蛋白质),对其进行定位、定性及相对定量的研究。普健生物提供石蜡切片和冰冻切片服务
服务优势
1.进口切片仪器,实验样本质量可靠
2.优化的实验步骤,确保排除假阳性,假阴性,实验标本长期保存
服务内容
|
服务内容 |
客户提供 | 服务步骤 | 服务周期 | 交付内容 |
|
IHC服务 |
组织或切片 待测抗原信息 待测抗原表达位置 |
组织固定和包埋 切片并固定 脱蜡 抗原修复 免疫组织化学染色,复染 脱水,封片 显微镜观察 |
2-3周 |
免疫组化切片 电子实验报告 |
案例展示
普健生物(武汉)科技有限公司于2012年在武汉成立,作为武汉国家生物产业基地指定的光谷抗体发现与筛选公共服务平台,具备优越的技术实力和国际化发展的战略格局,专注于重组蛋白、抗体、诊断原料、抗体药物发现等自主技术平台的建设和下游生物医药产品的战略合作。
公司大楼坐落于东湖新技术开发区神墩四路, 这里绿叶繁茂,道路宽敞,周围有一众生物科技型高新企业。普健生物作为一员加入此处,为周遭增添了一抹亮丽的色彩。
公司立足于生命科学领域,自主建立三大完善的技术服务平台:生命科学研究平台、诊断原料开发平台、抗体药物研发平台。生命科学平台:拥有五大成熟高效的蛋白表达系统(枯草芽孢杆菌、大肠杆菌、酵母、昆虫细胞、哺乳动物细胞),鼠/兔单克隆抗体平台,可提供蛋白表达、分子构建-蛋白表达纯化-结构解析、抗体重组表达、鼠/兔单克隆抗体制备以及相关检测服务。诊断原料开发平台:拥有开放式化学发光自动平台,可缩短研发周期、降低开发成本与技术风险,为广大客户提供各种诊断核心原料开发。抗体药物发现平台以杂交瘤筛选与噬菌体展示技术为主,目前已完成构建并对外提供抗体筛选技术服务的文库有:新冠特异性抗体噬菌体文库、羊驼天然纳米抗体噬菌体文库、兔源天然抗体噬菌体文库、小鼠天然抗体噬菌体文库。同时也开发了大量的重组蛋白、抗体、工具酶、药物对照抗体、工业酶、诊断原料等相关产品。
目前已拥有的自主技术包括:哺乳动物细胞重组蛋白表达系统、稳定细胞株构建、噬菌体文库的构建以及淘选、DNA免疫技术、化学发光免疫诊断抗体筛选技术等等。截止目前已成功交付数万例与重组蛋白、抗体相关的技术委托研发,客户以及合作伙伴涵盖了国内外优秀的学术研究机构以及制药公司;并且与FIND(创新诊断基金会)、BAYER(拜耳作物科学)、广州呼吸健康研究院建立合作关系;与青岛大学附属医院医学研究转化中心,苏州系统医学研究所,广州再生医学与健康广东省实验室建立战略合作关系。
如果您对我们的产品感兴趣,请联系我们。
